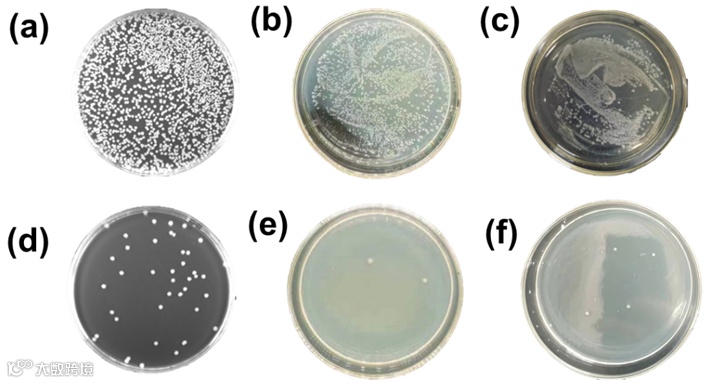

近年来,能源市场发生了巨大的变化,化石燃料正在被更清洁的能源所取代。核能具有技术成熟、成本低、可持续性等一系列的优点,与水电、光伏和风力发电相比,核能不存在供应间歇性,受自然条件限制较小。所以,它被认为是一种可以在很大程度上取代化石能源的清洁能源。然而,已探明的陆地铀矿只够现有的核电站运行80-120年,所以未来陆地铀燃料的匮乏无法避免。据统计,海水中含有铀约45亿吨,是陆地铀矿的几百倍。因此,从海水中提取铀是未来核能发展的重要一步。现在发展的从海水中提取铀的方法主要有吸附法、膜分离法、电化学萃取法,其中吸附法具有操作性好、应用范围广、经济效益高等多重优点。但是由于海水中铀浓度极低,且存在多种干扰金属离子和微生物种类,所以有必要开发一种新型高效吸附剂。

近日,郑州大学申长雨院士、刘春太教授团队的杨佩佩博士和李松伟博士课题组将采用氧化石墨烯(GO)和聚丙烯酰胺/聚丙烯酸(PAM/PAA)制备具有光热转化特性的水凝胶,用于从海水中高效提取铀。在PAM/PAA/GO水凝胶中引入两性离子2-甲基丙烯酰氧基乙基磷酸胆碱(MPC)得到PAM/PAA/GO/MPC(PAGM),具有良好的抗菌性能。PAGM展示了铀(VI)(U(VI))的有效和特异性吸附。光照条件下,PAGM的吸附容量达到196.12 mg g-1(pH = 8,t = 600 min, C0= 99.8 mg L-1, m/v = 0.5 g L-1)。吸附能力仅为160.29 mg g−1在黑暗条件下(pH = 8,t = 600 min,C0= 99.8 mg L-1, m/v = 0.5 g L-1)。光的吸附容量比暗光高22.5%。此外,PAGM在五次吸附-解吸循环后表现出良好的重复性和稳定性。在天然海水中储存一个月后PAGM的U(VI)吸附容量为6.1 mg g-1。X射线光电子能谱(XPS)结果表明, 氨基、羧基和羟基与U(VI)的配位是U(VI)吸附的主要机制,并通过详细的密度泛函理论计算证实了其机制。PAGM具有耐久性、高效率、光热转换性能和抗菌性能。
该工作以“Zwitterion functionalized graphene oxide/polyacrylamide/polyacrylic acid hydrogels with photothermal conversionand antibacterial properties for highly efficient uranium extraction from seawater” 为题发表在《Advanced Functional Materials》。文章第一作者是郑州大学硕士研究生李辉,该研究得到了国家自然科学基金项目和国家重点研发计划项目等项目的支持。
将GO引入PAM/PAA/MPC的水凝胶网络中制备PAGM。首先将丙烯酰胺(AM)、丙烯酸(AA)、N,N-亚甲基双丙烯酰胺(MBA)、MPC和适量GO溶解在蒸馏水中,在50℃搅拌至溶液均匀透明。然后将溶液自然冷却至室温。之后在上述溶液中加入四甲基乙二胺(TEMED)和过硫酸钾(KPS),于N2气氛下反应。最后将混合溶液置于冰浴中2h,得到PAGM水凝胶。

通过对比MPC与PAGM-1的FT-IR光谱,3434 cm-1处观测到的FT-IR峰可归结为GO的-OH和PAM/PAA的-OH/-NH,而1660和1170 cm-1处观测到的FT-IR峰则分别归属于酰胺基团和-C-O-C的C=O拉伸振动。在PAGM-1的FT-IR光谱中在1438和1236 cm −1处观察到两个峰,这证实了PAGM-1水凝胶的成功合成(图 2a)。此外,当调整PAGM的比例时,PAGM的FT-IR光谱并没有明显变化(图 2b)。图 2c拉曼表征表明PAM/PAA已经成功地利用共价键连接到GO上。如图 2d所示在PAGM-1复合材料的光谱中,20.8°处宽而弱的衍射峰显示PAM/PAA与GO的成功结合以及GO结晶度的降低。如图 2e所示,GO呈现出褶皱的纳米片结构,而PAGM-1(图 2f)、PAA/PAM水凝胶(图 2g)和PAGM-1(图 2h)水凝胶则呈现出明显的3D网络结构。

pH值是影响吸附剂吸附能力的重要因素。图 3a为测试pH对不同吸附剂的影响所进行的实验结果。在pH=1-8时,PAG和PAGM-1的吸附容量逐渐增大,其最大吸附容量分别为195.37和196.12 mg g-1,在pH=8-10时,PAG和PAGM-1的吸附容量略有下降,但仍高于GO和PAM/PAA。图 3b为GO含量对于PAGM吸附能力的影响。表明在GO含量为1%时,PAGM的吸附容量最高(196.12 mg g-1)是PAM/PAA的2.17倍(qe = 90.31 mg g-1)。图 3a和3b显示,光照条件下PAGM-1上铀酰离子的吸附量比黑暗条件下的吸附量高22.5%。这一结果可能归因于GO中碳原子之间存在较大的共轭体系,表现出宽频带的光学吸收,因此可以将光能转化为热能。图 3c-f是在模拟阳光照射下对材料进行了光热转换能力的测试,PAM/PAA的温度在5分钟内从29.9℃变化到36.5℃,而PAGM-1的温度在5分钟内从33.6℃变化到68.6℃,这证实了PAGM-1良好的转换能力。此外该文章还测试了吸附时间,吸附初始浓度对于吸附的影响。

图 3. pH值、GO浓度、模拟阳光对于吸附的影响
采用基于DFT的第一性原理方法探索了U(VI)在PAGM-1上的结合模式。开发并优化了PAGM-1、铀酰离子及其结合模型。优化后的结构如图 4所示。PAGM-1上的N-U键长为2.303 Å。与U结合的羧基和羟基中氧的键长分别为2.269和2.287 Å。PAGM-U的吸附能为−3423.69 kcal/mol。较短的键长和较高的结合能,证实了PAGM-1对U(VI)的吸附是一个化学吸附过程。通过分析分子范德华表面的静电势分布(图 9d-f)来预测每个位点最可能发生的化学反应类型。静电势越负或越正的原子,分别更容易发生亲电或亲核反应。在PAGM-U中,电子从铀酰离子转移到PAGM-1,表明PAGM-1与U(VI)之间存在显著的共价相互作用。

利用平板计数法对所制备的PAGM-1菌落进行抑菌效果评价。试验菌株选择为革兰氏阳性金黄色葡萄球菌、革兰氏阴性大肠杆菌和枯草芽孢杆菌。结果表明,与对照组相比,PAGM-1明显抑制了细菌的生长(图5)MPC是一种两性化合物,分别带有正电荷和负电荷的季铵盐和磷酸盐基团。将MPC引入到所研制的水凝胶中。当水凝胶因为阳离子特性而表现出抗菌特性时,其抗菌机制类似于“阴离子海绵”,即带正电荷的阳离子基团与带负电荷的细菌细胞壁结合,导致细菌细胞壁电荷失衡、破裂,最终抑制细菌生长,甚至杀死细菌。阴离子可以稳定地与水分子结合形成水合层,有效抑制细菌粘附。因此,PAGM-1表现出了良好的抗菌性能。

小结:在这项研究中,在水凝胶结构中引入两性MPC离子,制备了抑菌的PAM/PAA修饰的GO水凝胶。PAGM表现出良好的光热转换能力,可以大大地提高U(VI)的吸附能力。PAGM在光照下的吸附能力比在黑暗中获得的吸附能力高出22.5%。在存在众多干扰离子的情况下,U(VI)的去除率达到了95%。经过五个循环,PAGM依然保持高稳定性。该水凝胶对常见的细菌菌株如革兰氏阳性的金黄色葡萄球菌、革兰氏阴性的大肠杆菌和枯草杆菌表现出明显的抑制能力,证实了所开发的吸附剂在海洋中长期使用的潜力。利用XPS和DFT计算分析了U(VI)在PAGM-1上的吸附机制。氨基、羧基和羟基与U(VI)在吸附剂表面的配位是主要的吸附机制。因此,PAGM水凝胶可以被认为是未来提取铀的优良材料。
全文链接:
https://doi.org/10.1002/adfm.202301773
相关进展

高分子科技原创文章。欢迎个人转发和分享,刊物或媒体如需转载,请联系邮箱:info@polymer.cn

欢迎专家学者提供稿件(论文、项目介绍、新技术、学术交流、单位新闻、参会信息、招聘招生等)至info@polymer.cn,并请注明详细联系信息。高分子科技®会及时推送,并同时发布在中国聚合物网上。
欢迎加入微信群 为满足高分子产学研各界同仁的要求,陆续开通了包括高分子专家学者群在内的几十个专项交流群,也包括高分子产业技术、企业家、博士、研究生、媒体期刊会展协会等群,全覆盖高分子产业或领域。目前汇聚了国内外高校科研院所及企业研发中心的上万名顶尖的专家学者、技术人员及企业家。
申请入群,请先加审核微信号PolymerChina(或长按下方二维码),并请一定注明:高分子+姓名+单位+职称(或学位)+领域(或行业),否则不予受理,资格经过审核后入相关专业群。